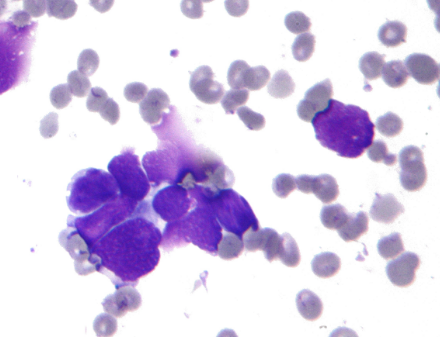

7种治疗肌萎缩侧索硬化症(ALS)的药物
肌萎缩性脊髓侧索硬化症(Amyotrophic l...
5款治疗转甲状腺素蛋白淀粉样变性病(ATTR)的药
淀粉样变性病(Amyloidosis)是指一种以β...
6款治疗鼻咽癌(NPC)的靶向药/免疫药
鼻咽癌(Nasopharyngeal carcin...
10款治疗滤泡性淋巴瘤(FL)的靶向药/特效药
滤泡性淋巴瘤(Follicular lymphom...
12种临床治疗食管癌(EC)的靶向药/免疫药物
食道癌(Esophagus cancer,EC)又...
44种治疗2型糖尿病(T2DM)的药物详情推荐
2型糖尿病(Diabetes Mellitus t...